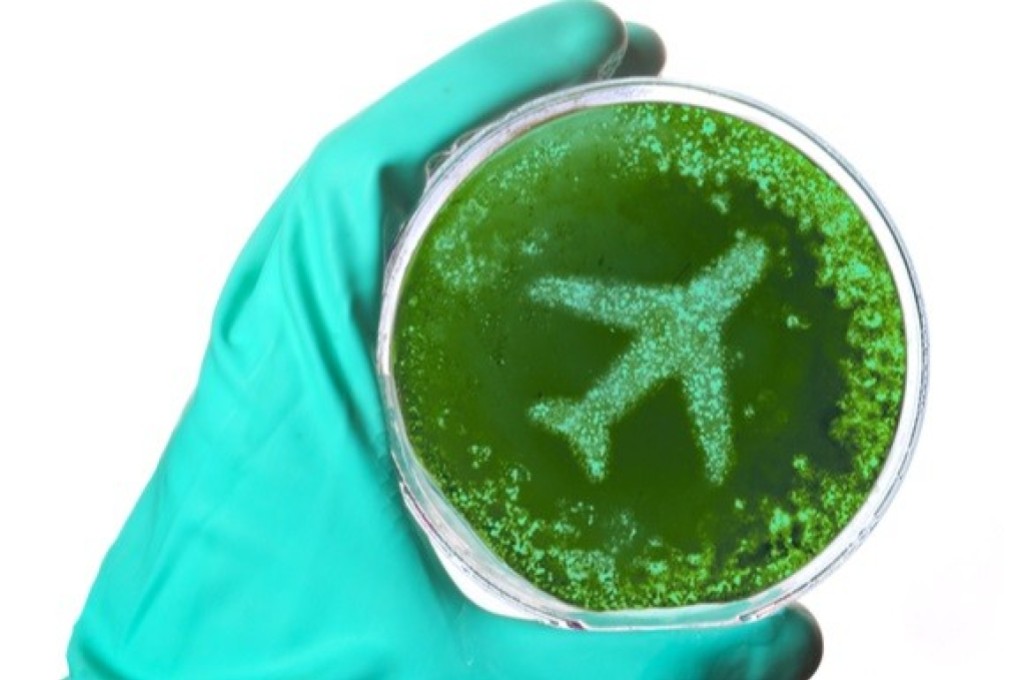
Aeroplanes are famously dirty, but there are tricks to avoid the germs

10 tips to keep you healthy on a plane amid spread of China coronavirus, flu and colds
- Winter travel is always slightly risky when it comes to physical well-being, but the coronavirus outbreak from Wuhan is an added worry
One of the biggest news stories so far this year has been the spread of the China coronovirus around the world – cases have been confirmed in the US, South Korea, Japan, Thailand and Macau. This disease has added stress to anyone planning to travel this winter, beyond the usual cold and flu season concerns.
Airports are taking steps to protect those passing through. In the US, passengers travelling to certain cities from the Chinese city of Wuhan will be screened for 2019 Novel Coronavirus, or “2019-nCoV”. Singapore authorities are screening passengers arriving on all flights from China. In India, Mumbai’s Chhatrapati Shivaji Maharak International Airport has increased surveillance measures. Delhi Airport staff are checking inbound passengers from affected areas.
That doesn’t mean travellers should not take added precautions to stay healthy at 30,000 feet.
What’s a travelling germophobe to do on a plane? Here are the top 10 tips.
1. Wash your hands often, with soap and water, for at least 20 seconds. The CDC says it is the single most important infection control measure, and it lists it first among the guidelines for preventing the spread of disease on commercial aircraft.
2. Carry alcohol-based hand sanitiser with you (at least 60 per cent alcohol) in case water isn’t easily available.
3. Avoid touching your eyes, nose and mouth with unwashed hands – you never know what you’ve touched.